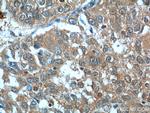
BCL7B Antibody in Immunohistochemistry (Paraffin) (IHC (P))

Search
Proteintech
BCL7B Polyclonal Antibody
{{$productOrderCtrl.translations['antibody.pdp.commerceCard.promotion.promotions']}}
{{$productOrderCtrl.translations['antibody.pdp.commerceCard.promotion.viewpromo']}}
{{$productOrderCtrl.translations['antibody.pdp.commerceCard.promotion.promocode']}}: {{promo.promoCode}} {{promo.promoTitle}} {{promo.promoDescription}}. {{$productOrderCtrl.translations['antibody.pdp.commerceCard.promotion.learnmore']}}
产品信息
11740-1-AP
种属反应
已发表种属
宿主/亚型
分类
类型
抗原
偶联物
形式
浓度
规格
纯化类型
保存液
内含物
保存条件
运输条件
产品详细信息
Immunogen sequence: MSGRSVRAE TRSRAKDDIK KVMAAIEKVR KWEKKWVTVG DTSLRIFKWV PVTDSKEKEK SKSNSSAARE PNGFPSDASA NSSLLLEFQD ENSNQSSVSD VYQLKVDSST NSSPSPQQSE SLSPAHTSDF RTDDSQPPTL GQEILEEPSL PSSEVADEPP TLTKEEPVPL ETQVVEEEED SGAPPLKRFC VDQPTVPQTA SES (1-202 aa encoded by BC000956)
靶标信息
Positive regulator of apoptosis. Plays a role in the Wnt signaling pathway, negatively regulating the expression of Wnt signaling components CTNNB1 and HMGA1. Involved in cell cycle progression, maintenance of the nuclear structure and stem cell differentiation. May play a role in lung tumor development or progression.
仅用于科研。不用于诊断过程。未经明确授权不得转售。
生物信息学
蛋白别名: B-cell CLL/lymphoma 7 protein family member B; B-cell CLL/lymphoma 7B; BCL tumor suppressor 7B; BCL7B; BCL7B, BAF complex component; unnamed protein product
基因别名: BCL7B; SMARCJ2
UniProt ID: (Human) Q9BQE9, (Mouse) Q921K9
Entrez Gene ID: (Human) 9275, (Rat) 368001, (Mouse) 12054